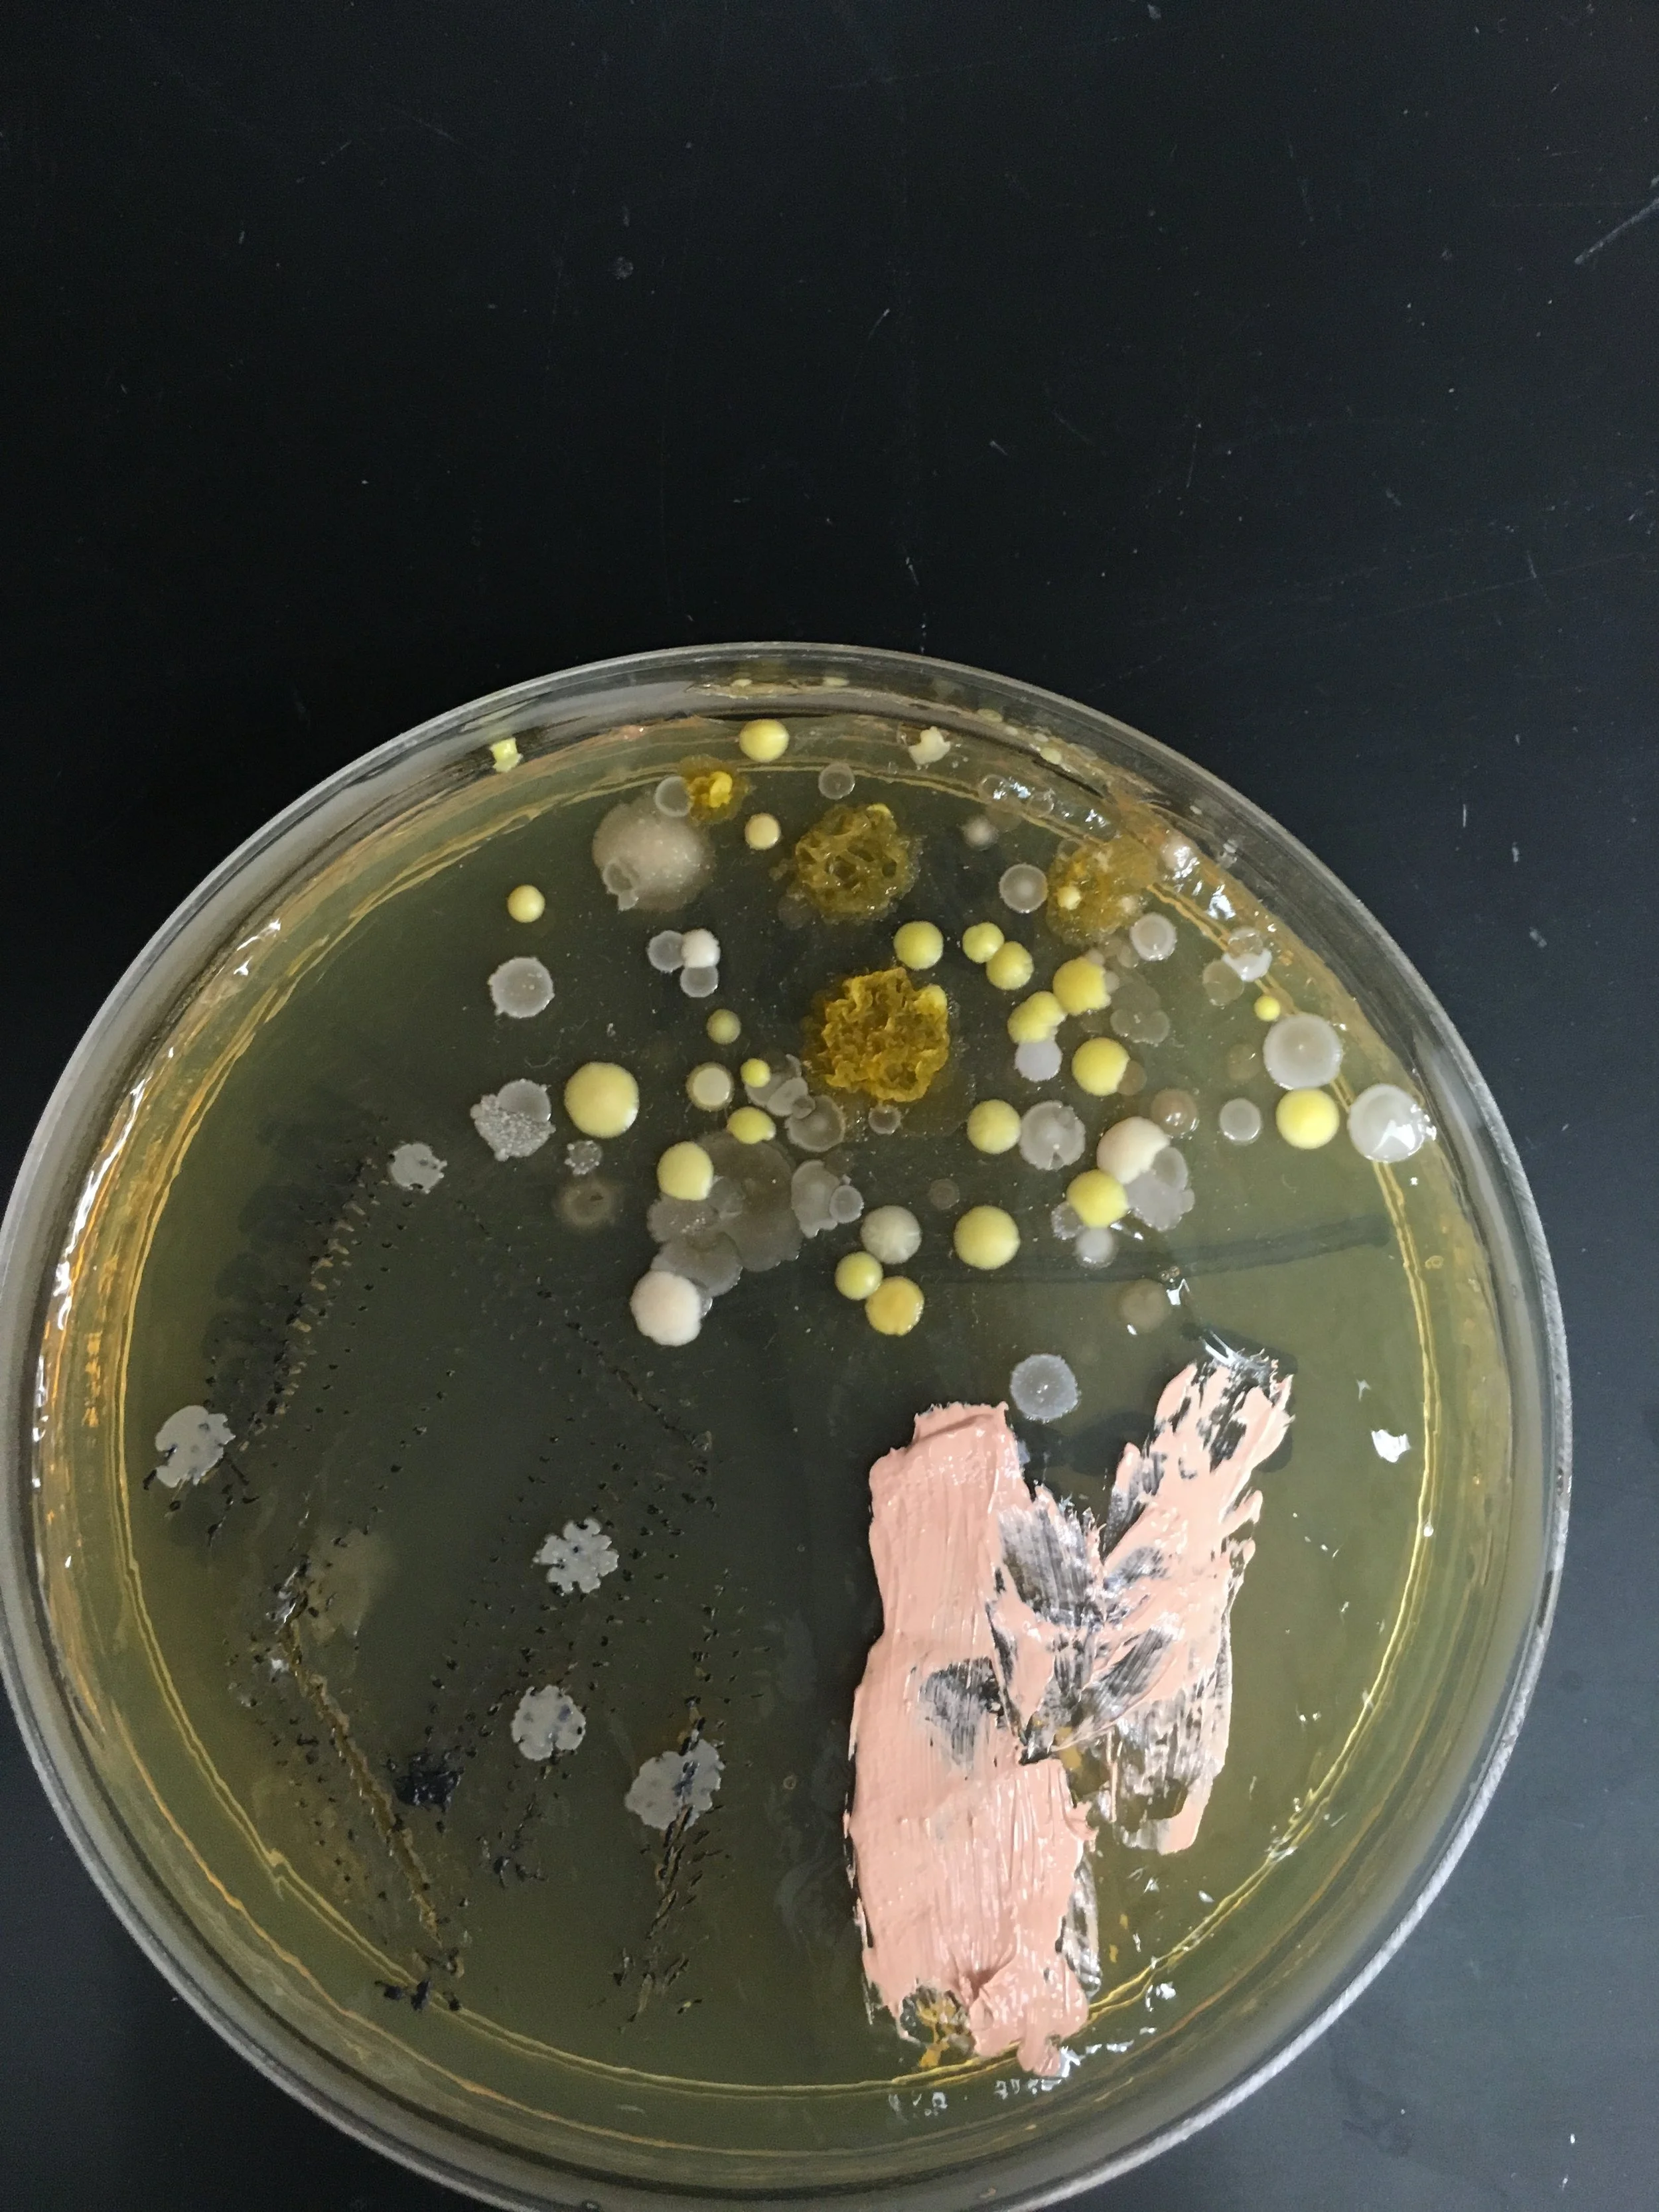

Work With Me
I help organizations turn complex science into real-world impact. With deep experience spanning clinical trial design, translational research, preclinical studies, and microbiome science, I bring both strategic vision and operational know-how. I’ve built and managed multimillion-dollar labs and research centers, overseen CRO partnerships, and navigated the maze of compliance, funding, and grant writing. At the same time, I’m a communicator and connector, whether speaking to scientific audiences, guiding teams through strategy, or translating discoveries into clear messages for broader outreach. My consulting services bridge the gap between vision and execution, ensuring that projects don’t just move forward but deliver lasting results.

Scientific Strategy & Operations
Clinical trial and translational study design
Preclinical program development
Microbiome and immunology expertise
Mechanistic hypothesis generation and biomarker development
Lab buildouts, space design, and commissioning
SOPs, regulatory, and compliance protocols (IACUC, biosafety, AAALAC)
CRO/vendor management and evaluation
Budgeting, resource allocation, and performance dashboards
Funding & Grant Advisory
Grant writing and review (NIH, foundations, SBIR/STTR)
Strategic alignment of funding priorities
Donor and philanthropic engagement strategies

Organizational Consulting
We believe values shouldn’t just live on posters. Whether you’re running a small business, a nonprofit, or simply want to strengthen your own leadership practice, we help you turn wellness, mentorship, and equity into measurable systems. Think of it like a dashboard for your people: clear signals, honest feedback, and proof that what you’re doing is actually working. From simple survey tools to ROI reports that show the real impact, we give you the structure to grow healthier teams and healthier leaders.
Bronze: Foundations
Best for: Small teams or departments ready to move beyond slogans.
Discovery call + needs assessment
Core Wellness / DEI / Mentorship KPIs identified
Custom survey design + lightweight dashboard template
One 2-hour leadership workshop on “Turning Values Into Metrics”
Email support for 30 days
One time fee
Silver: Growth
Best for: Mid-size organizations that want live dashboards + quarterly accountability.
Everything in Bronze, plus:
Implementation of a live dashboard
Quarterly ROI reports showing cost vs benefit
Mentorship Index or Wellness Index pilot (choose one focus area)
Two facilitated workshops with leadership + staff
3-month support retainer
Initial fee + monthly retainer
Gold: Transformation
Best for: Universities, hospitals, or enterprises that want institution-wide cultural change with proof.
Everything in Silver, plus:
Full People Metrics Suite (Wellness, DEI, Mentorship Indexes)
Integration with HRIS/time-tracking system
Annual People ROI Report (board/leadership-ready, with benchmarking)
Certification audit + “Values in Practice” recognition badge
Ongoing strategy advisory with executive team
Dedicated analyst support (monthly deep dives + custom dashboards)
Annual contract
Communication & Outreach
Scientific speaking (academic, industry, CME, public audiences)
Science communication and knowledge translation
Marketing and brand positioning for biotech/health companies
Educational program design (CME, workshops, outreach initiatives)
